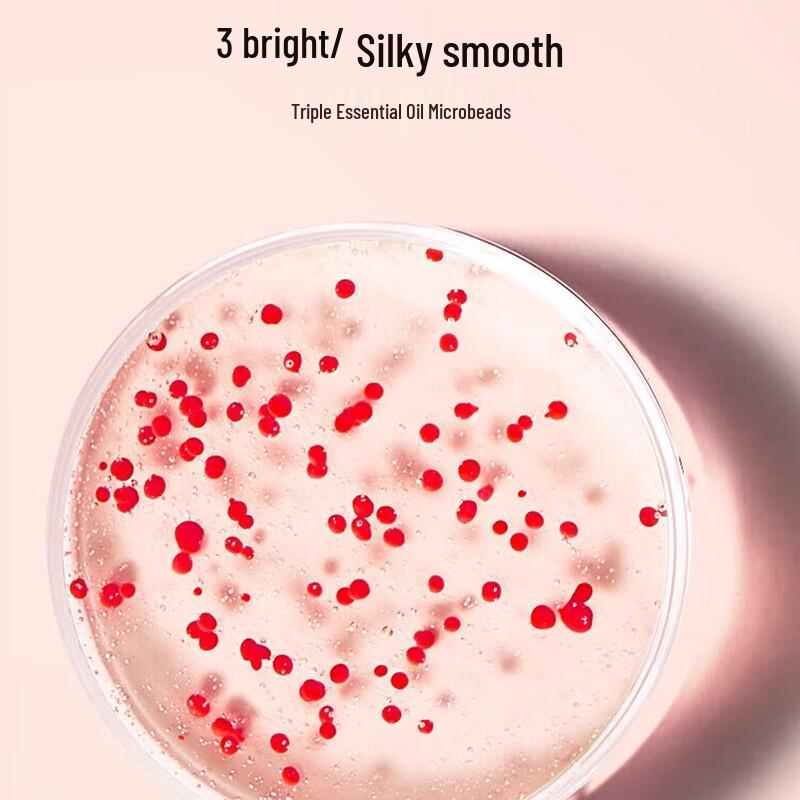
René Furterer Strengthening & Volumizing Shampoo

The website doesn't support your browser. Please update your browser or download a different one
René Furterer Strengthening & Volumizing Shampoo
Current price
Price €40.45VAT included

Model200ML - Shiny & Moisturized
Delivering across 🇬🇧 United Kingdom
6–11 business days · €3.47 per order
Your payments and privacy are safe






Safety & compliance
Characteristics
Shelf life
3 years
Description
JDST online
4.5/3,000+
Similar products